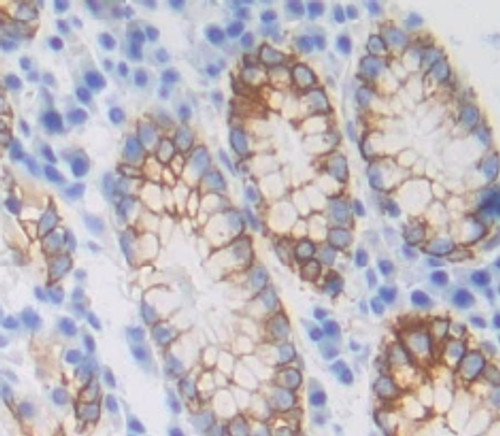

Target Name
Target Synonyms
Species
Species Reactivity
Host
Clonality
Immunogen
IHC Validation
Applications
tid
The Beta-1,3-Galactosyltransferase 5 (b3GALT5) Polyclonal Antibody (Species: Human) has been validated for the following applications: WB, IHC, ICC, IP. Host: Rabbit. Species: Human (Homo sapiens). Immunogen: Asn29~Val310. Applications: WB, IHC, ICC, IP. Accession Number: Q9Y2C3. Gene ID: 10317. Target Synonyms: B3GalT-V; B3GalTx; B3T5; GLCT5; beta3Gal-T5; UDP-Gal:beta-GlcNAc beta-1,3-galactosyltransferase 5; UDP-galactose:beta-N-acetylglucosamine beta-1,3-galactosyltransferase 5 Restrictions: For Research Use Only. Not for use in diagnostic procedures.
Lead Time
Accession Number
Gene ID
Conjugate
Applications
Purification
Concentration
Format
Storage
Buffer
Expiration
Shipping Condition
Research Area
Quality Guarantee
Restrictions
Quality Systems
Technical Documents
Selected Citations Featuring Biomatik's Products & Services
Last updated 2020-01-31
- Nature Communications, 10(1): 3667. (2019). PMID: 31413255
Title: PTPσ inhibitors promote hematopoietic stem cell regeneration
Product/Service Type: ELISA Kits - Immunity, 50(2): 446-461.e9. (2019). PMID: 30709742
Title: Microbiota Sensing by Mincle-Syk Axis in Dendritic Cells Regulates Interleukin-17 and -22 Production and Promotes Intestinal Barrier Integrity
Product/Service Type: Biochemicals - Science, 364(6436): pii: eaav0748. (2019). PMID: 30975858
Title: Glycosidase and glycan polymorphism control hydrolytic release of immunogenic flagellin peptides
Product/Service Type: Custom Gene Synthesis Service - Nature, 577: 689-694. (2020). PMID: 31942068
Title: VEGF-C-driven lymphatic drainage enables immunosurveillance of brain tumours
Product/Service Type: Custom Peptide Synthesis Service - Neuron, 102(2): 420-434.e8. (2019). PMID: 30826183
Title: Distinct Modes of Presynaptic Inhibition of Cutaneous Afferents and Their Functions in Behavior
Product/Service Type: Custom Antibody Production Service - PNAS, 115(51): E12005-E12014. (2019). PMID: 30509983
Title: Mycoplasma promotes malignant transformation in vivo, and its DnaK, a bacterial chaperone protein, has broad oncogenic properties
Product/Service Type: Custom Protein Expression & Purification Service
Click here to view more selected publications citing Biomatik's fine products & services. .
Click Google Scholar to view 3,000+ publications citing Biomatik's fine products & services. .

To edit this page simply login to the control panel, click the Website Content tab and choose the View Web Pages option. Click Edit next to the Shipping & Returns page and you can change this text. A sample returns policy is shown below which you can edit as needed.
Returns Policy
You may return most new, unopened items within 30 days of delivery for a full refund. We'll also pay the return shipping costs if the return is a result of our error (you received an incorrect or defective item, etc.).
You should expect to receive your refund within four weeks of giving your package to the return shipper, however, in many cases you will receive a refund more quickly. This time period includes the transit time for us to receive your return from the shipper (5 to 10 business days), the time it takes us to process your return once we receive it (3 to 5 business days), and the time it takes your bank to process our refund request (5 to 10 business days).
If you need to return an item, simply login to your account, view the order using the "Complete Orders" link under the My Account menu and click the Return Item(s) button. We'll notify you via e-mail of your refund once we've received and processed the returned item.
Shipping
We can ship to virtually any address in the world. Note that there are restrictions on some products, and some products cannot be shipped to international destinations.
When you place an order, we will estimate shipping and delivery dates for you based on the availability of your items and the shipping options you choose. Depending on the shipping provider you choose, shipping date estimates may appear on the shipping quotes page.
Please also note that the shipping rates for many items we sell are weight-based. The weight of any such item can be found on its detail page. To reflect the policies of the shipping companies we use, all weights will be rounded up to the next full pound.
Integer et est tellus non bibendum est. Namcos tempus turpis at metus scelerisque placerat nulla eu sollicitudin felis. Pellentesque diam dolor elementum et lobortis at mollis ut risus. Sed faucibus ullamcorper mattis. Fusce molestie elit a loremos tempus scelerisque blandit tortor cursus. Quisque dolutpat orci ut metus malesuada lorem in interdum lectus scelerisque. Praesent eu odio ut nisi ullamcorper ultricies. Cum sociis natoque penatibus et magnis dis parturient montes, nascetur ridiculus mus.
Praesent at justo congue leo adipiscing
- Integer et est tellusInteger et est tellus non bibendum est.
- Namcos tempusNamcos tempus turpis at metus scelerisque placerat nulla eu sollicitudin felis.
- Pellentesque diam dolorPellentesque diam dolor elementum et lobortis at mollis ut risus.
- Sed faucibusSed faucibus ullamcorper mattis.
- Fusce molestie elitosFusce molestie elit a loremos tempus scelerisque blandit tortor cursus.
- Quisque dolutpat orcisQuisque dolutpat orci ut metus malesuada lorem in interdum lectus scelerisque.
- Praesent an modioPraesent eu odio ut nisi ullamcorper ultricies.
- Cum sociis natoque penatibusCum sociis natoque penatibus et magnis dis parturient montes, nascetur ridiculus mus.